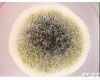
瓶、袋、箱、盒 <em>甲基</em>红<em>试剂</em>

甲基托布津 Thiophanate-methyl 亿欣化工试剂
- 型号:23564-05-8
- 产地:其它
- 供应商:上海亿欣化工环保科技有限公司
- 供应商报价:电议
- 标签:甲基托布津 Thiophanate-methyl 亿欣化工试剂,生物试剂,生物制剂,供应甲基托布津 Thiophanate-methyl 亿欣化工试剂,上海亿欣化工环保科技有限公司
详细说明:
| 别名 | 1,2-二-(3-甲氧羰基-2-硫脲基)苯;甲基硫菌灵;1,2-双-(甲氧羰基-2-硫脲基)苯;甲基多保净 1,2-Bis(3-(methoxycarbonyl)-2-thioureido)benzene;Dimethyl (1,2-phenylenebis(iminocarbonothioyl))bis(carbamate) |
| CAS号: | 23564-05-8 |
| 级别: | 分析纯 |
| 性状: | 白色或淡黄色晶体,熔点177~178℃(分解),易溶于二甲基甲酰胺、氯仿;可溶于丙酮、甲醇、乙醇、乙酸乙酯、二氧六环;难溶于水。对酸、碱稳定 |
| 用途: | 生化研究。广谱性杀菌剂,广泛用于稻、棉、麦、油菜等多种作物多种病害FZ |